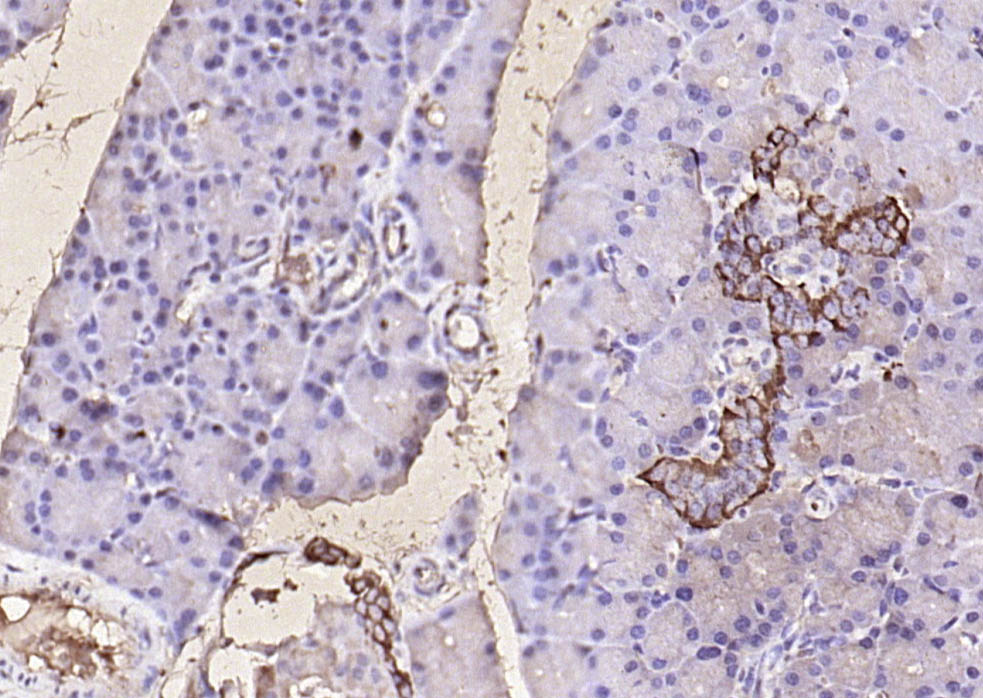
产品细节图片1

相关产品推荐更多 >

HDAC11 Recombinant Rabbit mAb(bsm-61104R)-50ul/100ul/25ul
¥800
Anti-human TNFSF13 / APRIL / CD256 (BION-1301 Biosimilar)(BIO0094SM)-1mg/5mg/20mg
¥3200
Beclin 1 Rabbit pAb, Cy5 conjugated(bs-1353R-Cy5)-100ul
¥2980
C20orf43 Rabbit pAb(bs-9700R)-50ul/100ul/200ul
¥1180
GRAMD1C Rabbit pAb, Biotin conjugated(bs-16308R-Bio)-100ul
¥2980
万千商家帮你免费找货
0 人在求购买到急需产品
- 详细信息
- 文献和实验
- 技术资料
- 应用范围:
产品信息以Bioss网站为准
- 规格:
50ul/100ul/200ul
| 规格: | 50ul | 产品价格: | ¥1180.0 |
|---|---|---|---|
| 规格: | 100ul | 产品价格: | ¥1980.0 |
| 规格: | 200ul | 产品价格: | ¥2800.0 |
| 产品编号 | bs-0933R |
| 英文名称 | GLP-1 Rabbit pAb |
| 中文名称 | 胰高血糖素样肽-1抗体 |
| 英文别名 | GCG; GLP 1; glucagon; Glucagon like peptide 1; GRPP; GLP-1(7-36); GLP-1(7-37); Oxyntomodulin; OXM; OXY; GLUC_HUMAN |
| 产品应用 | IHC-P=1:100-500, IHC-F=1:100-500, IF=1:100-500 Not yet tested in other applications. |
| 交叉反应 | Human, Mouse, Rat |
| 抗体来源 | Rabbit |
| 免疫原 | KLH conjugated synthetic peptide derived from human GLP-1 |
| 亚型 | IgG |
| 性状 | Liquid |
| 纯化方法 | affinity purified by Protein A |
| 克隆类型 | Polyclonal |
| 理论分子量 | 21 kDa |
| 浓度 | 1mg/ml |
| 储存液 | 0.01M TBS (pH7.4) with 1% BSA, 0.02% Proclin300 and 50% Glycerol. |
| 研究领域 | Cancer > Cancer Metabolism > Metabolic signaling pathway > Integration of energy metabolism Cancer > Tumor biomarkers > Hormones Developmental Biology > Lineage specification > Endoderm Metabolism > Pathways and Processes > Metabolic signaling pathways > Energy transfer pathways > Integration of energy Metabolism > Types of disease > Cancer Signal Transduction > Growth Factors/Hormones > Hormones Stem Cells > Lineage Markers > Endoderm |
| 亚基 | Secreted. |
| 亚细胞定位 | Secreted. |
| 组织特异性 | Glucagon is secreted in the A cells of the islets of Langerhans. GLP-1, GLP-2, oxyntomodulin and glicentin are secreted from enteroendocrine cells throughout the gastrointestinal tract. GLP1 and GLP2 are also secreted in selected neurons in the brain. |
| 翻译后修饰 | Proglucagon is post-translationally processed in a tissue-specific manner in pancreatic A cells and intestinal L cells. In pancreatic A cells, the major bioactive hormone is glucagon cleaved by PCSK2/PC2. In the intestinal L cells PCSK1/PC1 liberates GLP-1, GLP-2, glicentin and oxyntomodulin. GLP-1 is further N-terminally truncated by post-translational processing in the intestinal L cells resulting in GLP-1(7-37) GLP-1-(7-36)amide. The C-terminal amidation is neither important for the metabolism of GLP-1 nor for its effects on the endocrine pancreas. |
| 相似性 | Belongs to the glucagon family. |
| 功能 | Glucagon plays a key role in glucose metabolism and homeostasis. Regulates blood glucose by increasing gluconeogenesis and decreasing glycolysis. A counterregulatory hormone of insulin, raises plasma glucose levels in response to insulin-induced hypoglycemia. Plays an important role in initiating and maintaining hyperglycemic conditions in diabetes.
GLP-1 is a potent stimulator of glucose-dependent insulin release. Play important roles on gastric motility and the suppression of plasma glucagon levels. May be involved in the suppression of satiety and stimulation of glucose disposal in peripheral tissues, independent of the actions of insulin. Have growth-promoting activities on intestinal epithelium. May also regulate the hypothalamic pituitary axis (HPA) via effects on LH, TSH, CRH, oxytocin, and vasopressin secretion. Increases islet mass through stimulation of islet neogenesis and pancreatic beta cell proliferation. Inhibits beta cell apoptosis. GLP-2 stimulates intestinal growth and up-regulates villus height in the small intestine, concomitant with increased crypt cell proliferation and decreased enterocyte apoptosis. The gastrointestinal tract, from the stomach to the colon is the principal target for GLP-2 action. Plays a key role in nutrient homeostasis, enhancing nutrient assimilation through enhanced gastrointestinal function, as well as increasing nutrient disposal. Stimulates intestinal glucose transport and decreases mucosal permeability. Oxyntomodulin significantly reduces food intake. Inhibits gastric emptying in humans. Suppression of gastric emptying may lead to increased gastric distension, which may contribute to satiety by causing a sensation of fullness. Glicentin may modulate gastric acid secretion and the gastro-pyloro-duodenal activity. May play an important role in intestinal mucosal growth in the early period of life |
| 保存条件 | Shipped at 4℃. Store at -20℃ for one year. Avoid repeated freeze/thaw cycles. |
| 注意事项 | This product as supplied is intended for research use only, not for use in human, therapeutic or diagnostic applications. |
| 背景资料 | Glucagon plays a key role in glucose metabolism and homeostasis. Regulates blood glucose by increasing gluconeogenesis and decreasing glycolysis. A counterregulatory hormone of insulin, raises plasma glucose levels in response to insulin-induced hypoglycemia. Plays an important role in initiating and maintaining hyperglycemic conditions in diabetes. |
| 应用 | 推荐稀释比例 |
| {IHC-P} | {1:100-500} |
| {IHC-F} | {1:100-500} |
| {IF} | {1:100-500} |

风险提示:丁香通仅作为第三方平台,为商家信息发布提供平台空间。用户咨询产品时请注意保护个人信息及财产安全,合理判断,谨慎选购商品,商家和用户对交易行为负责。对于医疗器械类产品,请先查证核实企业经营资质和医疗器械产品注册证情况。
文献和实验[IF={{ 4.5 }}] {Pengfei Lv. et al. Intestinal Perfusion of Unacylated Ghrelin Alleviated Metabolic Associated Fatty Liver Disease in Rat via a Central Glucagon-Like Peptide-1 Pathway. AM J PHYSIOL-GASTR L. 2024 Apr;(Articles in Press):} {IHC,IF} {Rat}
[IF={{ 1.918 }}] {Haili Zhang. et al. Morphological changes in the digestive tract of the Chinese soft-shelled turtle (Pelodiscus sinensis) during embryonic development. J HISTOTECHNOL. 2022 Aug 01} {IHC} {Chicken}
= NAL), appears to form upon oxidative cyclization of the nonfluorescent 2:1 lysine-HNE Michael adduct-Schiff base cross-link (Scheme 1). Polyclonal antibody (PAb) to the NAL-HNE fluorophore was raised in rabbit and found to be highly specific
GE Healthcare Benzamidine Sepharose™ 6B is p-aminobenzamidine covalently attached to Sepharose 6B by the epoxy coupling method. p-Aminobenzamidine (PAB), is a synthetic inhibitor of trypsin-like serine protease. Trypsin and trypsin
Nucleic Acid Programmable Protein Arrays: Versatile Tools for Array‐Based Functional Protein Studies
.g., Sigma) 50 mg/ml bis‐sulfosuccinimdylsuberate (BS3 ;Pierce, cat. no. PI 21580) in dimethylsulfoxide (DMSO) 5 mg/ml
技术资料暂无技术资料 索取技术资料





